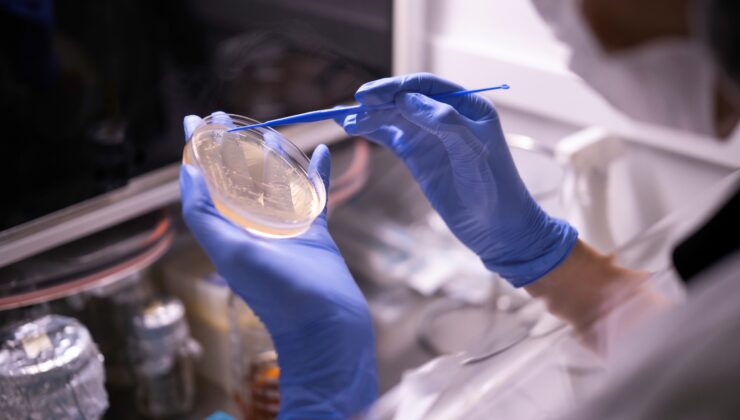
Ar-Ge yatırımıyla Türkiye’nin ilk 250 firması arasında

Ekonomi ve iş dünyası portalı Turkishtime’ın gelenekselleşen Türkiye Ar-Ge 250 Araştırması’nın 2024 verileriyle hazırlanan sonuçları açıklandı. Türkiye ihracat sıralamasındaki ilk 500 firmaya, Bilim, Sanayi ve Teknoloji Bakanlığı’na kayıtlı Ar-Ge merkezi bulunan firmalara ve Ar-Ge datalarını Kamu Aydınlatma Platformu’yla paylaşan firmalara yönelik anket verileriyle hazırlanan araştırma sonuçlarına göre Orzaks’ın üretim gücü olan Nuvita İlaç, performansıyla ilk 250 firma arasında yer aldı.

Kalite anlayışı ve uluslararası standartlara uygun üretim felsefesiyle bilime dayalı Ar-Ge faaliyetleri yürüten Nuvita İlaç, geçen seneki araştırmada ilk 500 şirket arasındayken, bu yılki Ar-Ge yatırımlarında performansını artırarak ilk 250 listesinde yer aldı.
Orzaks’ın üretim şirketi Nuvita İlaç, Ar-Ge harcamalarını son 4 yılda 10 kat artırdı. Toplamda 100 milyon TL’yi aşan yatırımlarıyla, bilime ve inovasyona verdiği somut desteği ortaya koyan Nuvita İlaç’ın Ar-Ge Merkezi’nde halen 38 proje yürütülüyor. Bugüne kadar 9 kamu projesinin tamamlandığı merkezde 2 kamu projesine yönelik geliştirme çalışmaları ise devam ediyor. Nuvita İlaç’ın 2023’te 2, 2024’te 9 olmak üzere 11 patent başvurusu bulunuyor.
Nuvita İlaç Ar-Ge Müdürü Akif Kavak, Turkishtime Türkiye Ar-Ge 250 Araştırması’nın sonuçlarını değerlendirdi. Nuvita İlaç’ın, şirket dinamikliğini sağlamak, değişen pazar taleplerini karşılamak ve stratejik önemdeki hammaddelerin üretimi için Ar-Ge’ye önemli yatırımlar yaptığını belirten Kavak, şöyle devam etti:

“Ar-Ge ve inovasyona yaptığımız yatırımlarla, şirketimizin büyümesinin yanında ülkemizin kalkınma hedeflerini de destekliyoruz. Tüm bu faaliyetlerimizle bilimsel bilginin ekonomik değere dönüştürülmesini sağlayarak hem akademiye hem de özel sektöre katkı sunuyoruz. Orzaks’ın da üretim faaliyetlerini sürdürdüğü Ar-Ge merkezimizde devam eden inovatif projelerimiz ve patent başvurularımızla literatüre ve sektöre kalıcı değerler kazandırıyoruz. Özellikle stratejik hammaddelerin üretimi konusundaki çalışmalarımızla ülkemizin ihtiyacına cevap verirken, insan sağlığına değer katacak yenilikçi çözümler geliştirmeye devam edeceğiz.”
GÜNDEM KORİDORU
8 gün önceGÜNDEM KORİDORU
14 gün önceGÜNDEM KORİDORU
14 gün önceGÜNDEM KORİDORU
14 gün önceGÜNDEM KORİDORU
15 gün önceEKONOMİ
21 gün önceEKONOMİ
25 Haziran 2026Veri politikasındaki amaçlarla sınırlı ve mevzuata uygun şekilde çerez konumlandırmaktayız. Detaylar için veri politikamızı inceleyebilirsiniz.